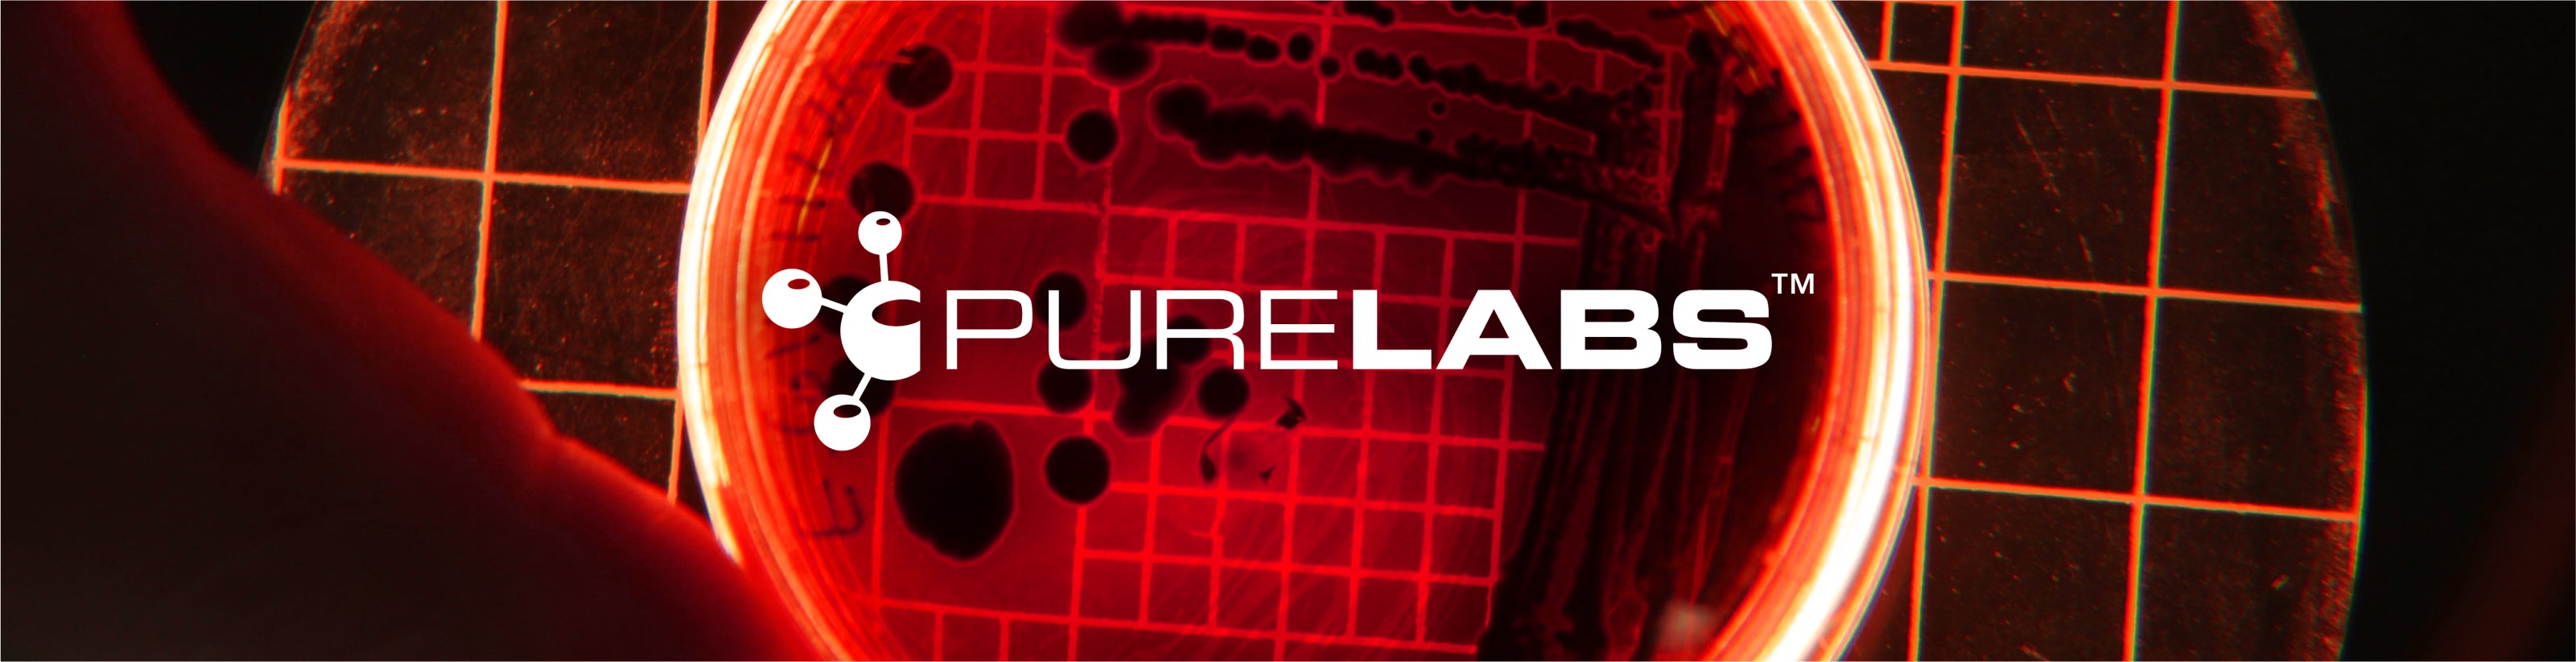
Pure Labs Product Collection

Amazing product love th conpany aswell fast shipping and got cool free shaker aswell
Filters
13 products
Pure Labs
Pure Labs collection at Pro Hormones, your premier destination for cutting-edge, high-strength sports nutrition and performance supplements. Pure Labs is synonymous with innovation, delivering maximum-strength, quality-tested formulas designed to push past your plateaus, whether you are focused on building lean muscle, incinerating body fat, or achieving peak workout performance.
This collection is expertly curated for the serious athlete who seeks superior, noticeable results across every phase of their training. For those focused on achieving maximum muscle and strength support, we proudly feature the advanced Alpha Male formula, a flagship product renowned among advanced users for its powerful composition. When it’s time to hit the gym with uncompromising intensity, unleash the power of Kingslayer Pre Workout, meticulously formulated to maximise focus, deliver explosive energy, and generate skin-splitting vascularity, ensuring every session is your absolute best.
Furthermore, we stock essential support formulas to help you maintain your gains and protect your health. For on-cycle support, rely on Cycle Shield, a vital blend of antioxidants and natural ingredients designed to protect your liver, support blood pressure, and help regulate cholesterol levels while using advanced muscle-building compounds. Once your cycle is complete, ensure you keep your progress with Clomadex, an advanced post-cycle therapy supplement that helps restore natural hormone balance, control cortisol, and minimise side effects, making it a perfect complement for any serious cycle.
Stop settling for less, explore the full range of Pure Labs supplements today and unlock the next level of strength, performance, and physical transformation.
Fast Shipping
Fast Global Shipping With Reliable Couriers
Customer Service
Contact Our Supplement Experts By Email
Secure Payment
Check Out With Confidence With Trusted Payment Gateways
















